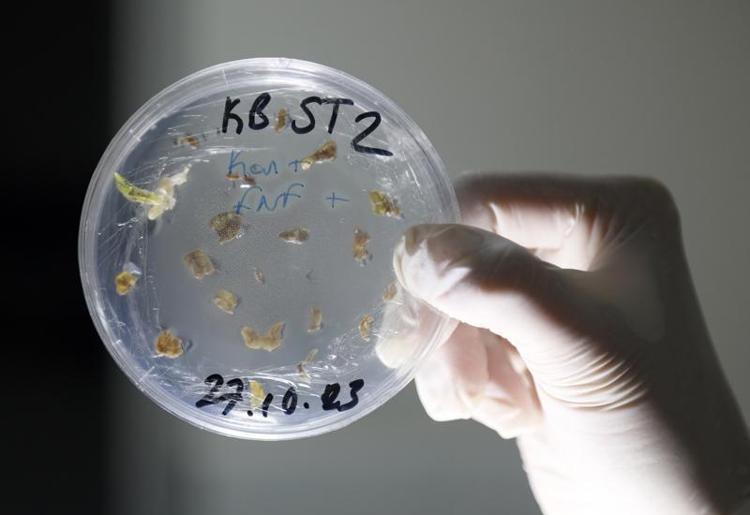

Domates, Nobel ödüllü yöntemle hastalıklara dayanıklı ve daha verimli olacak
Antalya'da, 2020 yılında Nobel ödülü alan CRISPR/Cas9 teknolojisinden yola çıkan Batı Akdeniz Tarımsal Araştırma Enstitüsü Müdürlüğü (BATEM) Ziraat Yüksek Mühendisi Kübra Yıldız, domatesin genetiğinde hastalıklara yol açan kısımları mutasyonla değiştirip hem dayanıklı hem de daha verimli hale getirdi.

Tarım ve Orman Bakanlığı'na bağlı BATEM'de görevli Ziraat Yüksek Mühendisi Kübra Yıldız, bitki sağlığı alanında Ar- Ge çalışmaları yapıyor. Özellikle üreticilerden gelen talepler doğrultusunda çalışmalarına yön veren Yıldız, bitkilerin hastalık etmenlerine karşı savunma geliştirmeleri ve daha dayanıklı olabilmeleri için 2020 yılında Nobel Kimya Ödülü verilen CRISPR/Cas9 yönteminden yola çıktı. CRISPR/Cas9 teknolojisi, bazı bakterilerin virüslere immünolojik savunmasında önemli rol oynayan bir protein yapısı olarak dikkati çekiyor. Bu protein mekanizmasının genetik mühendisliği uygulamalarında bir hücrenin genomunu değiştirmek için yoğun olarak kullanılmasını örnek alarak uygulayan Yıldız, bitkiler üzerine çalışmaya başladı. Özellikle domatesi hastalıklara daha dayanıklı ve virüslere karşı kendini onaran ve savunan bir duruma getirmeye çalışan Yıldız, bu şekilde meydana gelecek verim kaybının da kısa sürede ortadan kalkacağını anlattı.

Bu yöntemin çok sayıda çalışmaya rol model olduğunu söyleyen Kübra Yıldız, “Antalya'da üretim alanlarında en çok hastalık yapan iki faktörü seçtik. Begomavirus grubu ve domatesteki külleme hastalığı. Bu ikisi de üretimi yüzde 60-70 oranında düşürmekte olup şimdilerde meyvelerini almaya başladık. Bitki çeşitlerimiz büyümeye başladı" dedi.
‘BAKTERİYE NEYİ YÜKLERSENİZ, O BİTKİNİN GENOMUNDAKİ SORUNU ORTADAN KALDIRIYOR’
Yıl sonuna kadar dayanıklı bitki çeşidini ve tohumu elde etmeyi hedeflediklerini de belirten Kübra Yıldız, “Bu bakteri bir terzinin makası gibi. O bakteriye neyi yüklerseniz o gidip bitkinin genomundaki sorunu ortadan kaldırıyor. Bugüne kadar çok sayıda genetik düzenleme aracı vardı ama bunlar genetiği değiştirilmiş organizma olarak adlandırılıyordu. Ancak biz CRISPR/Cas9 modelinde GDO olmayan ve güneşin bile yapabileceği bir mutasyona sebep olarak GDO olmayan son ürün elde edebiliyoruz. 10 yılda klasik ıslah çalışmalarıyla yapılacak dayanıklı bitkiyi biz bu yöntemle en fazla 1 yılda hazırlıyoruz" diye konuştu.
Yıldız, bu yöntemin yasal süreçleri tamamladığında, tohum formunda üreticiye verilecek ürünle sağlıklı bitkilerin daha verimli halde kazandıracağını sözlerine ekledi.

CRISPR-CAS9 NEDİR?
Nobel Kimya Ödülü 2020 yılında, DNA zincirlerini kesmeye ve yeniden birleştirmeye olanak sağlayan 'CRISPR-Cas9' sisteminin geliştirilmesine katkılarından dolayı, Fransız mikrobiyolog Emmanuelle Charpentier ile ABD'li biyokimyacı Jennifer A. Doudna'ya verildi. 'DNA'da Ameliyat Yapabilen Teknoloji' olarak da anılan CRISPR-Cas9, 2020 Nobel Kimya Ödülü ile bilim dünyasında heyecan yaratan bir uygulama.

CRISPR-Cas9, bir genom düzenleme aracı. Genetikçilerin ve tıp araştırmacılarının DNA üzerinde ekleme, çıkarma yapmalarına ya da DNA dizilimini değiştirmelerine olanak tanıyan özgün bir teknoloji. Bugüne kadar kullanılan tekniklerin hepsinden daha hızlı, daha ucuz ve daha yüksek doğruluk oranına sahip olan CRISPR-Cas9, geniş bir uygulama yelpazesine sahip.




